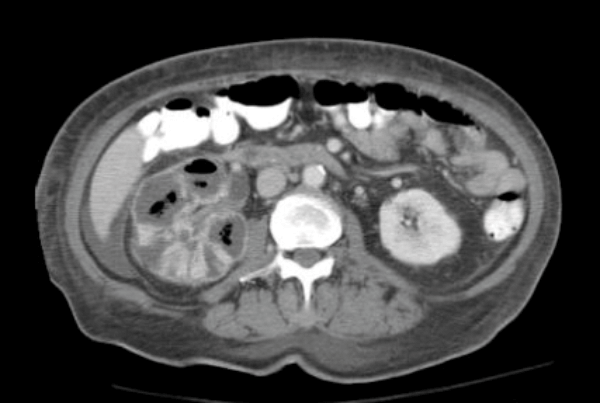

See also Part 1 and Part 2
Case 1
You review a man in the Emergency Department with scrotal pain and sepsis. His clinical examination findings are shown.

- What does this image show?
- Who was this condition named after?
- What is the pathophysiology?
- Name some risk factors?
- What antibiotics would you prescribe pre surgery and why?
Case 2
Below is a selection of radiological images of the urinary tract.


Figure 1.

Figure 2a.

Figure 2b.
- What do the two clinical images represent in Figure 1?
- What are the possible causes?
- Figure 2 shows other radiological features of one of these possible causes. What is the likely diagnosis? How often does this condition affect the urinary tract?
- What pathology can it cause in the urinary tract?
- What are the ‘classical features’ seen on an intravenous urogram (IVU)?
Case 3
These are a series of radiological images highlighting serious urological infections.

A.

B.
C.
- What are the radiological diagnoses from these images?
- What are the causes of air in the urinary tract?
- Which organisms commonly cause gas in the urinary tract and why?
- Can you define a classification system for emphysematous pyelonephritis?
Infections and inflammation: part 3 - answers
Case 1
-
Fournier gangrene.
-
French venereologist, Jean Alfred Fournier.
-
Polymicrobial, synergistic infection resulting in necrotising fasciitis of the genitals and perineum. This results in local microvascular thrombus and local hypoxia, leading to further infection with anaerobic organisms. This results in subcutaneous necrosis, which then rapidly spreads through the tissue plains.
-
Diabetics, malnutrition, malignancy, IV drug users, immunocompromised, alcoholics, renal failure.
-
Broad spectrum antibiotic cover is needed. One regime is: Vancomycin (covers MRSA / gram positive), clindamycin (Group A strep, gram positive and anaerobes) and meropenem (Gram positive / negative, anerobes).
Case 2
-
Papillary necrosis.
-
POSTCARDS: Pyelonephritis, Obstruction, Sickle cell disease, TB, Cirrhosis, Analgesia abuse, Renal vein thrombosis, Diabetes, Systemic vasculitis.
-
TB, 15% genitourinary tract involvement. A: left autonephrectomy, B: non-functioning right kidney with left sided infundibular scarring and caliectasis, left distal ureteric stricture, small capacity bladder.
-
Kidney (haematogenous spread): infundibular stenosis and calyceal dilatation, papillary necrosis, ‘putty’ kidney, autonephrectomy. Ureter: lower ureteric strictures, gold hole ureteric orifice. Bladder: ‘thimble’ bladder, calcification, reduces capacity. Rarer: prostatitis, urethritis, epidydmitis (string of beads), orchitis.
-
Renal calcification, infundibular stenosis, autonephrectomy, ureteric calcification / strictures, calcified bladder, small volume bladder.
Case 3
-
a: emphysematous prostatitis
b: emphysematous cystitis
c: emphysematous pyelonephritis.
-
Recent instrumentation, fistula from genitourinary tract, trauma, infarctions (spontaneous / elective), urinary diversions, infections.
-
e.coli, candida, klebsiella, proteus. These organisms can cause sugar fermentation and release of carbon dioxide.
-
Huang-Tseng CT classification:
Class 1: gas in collecting system
Class 2: gas in parenchyma
Class 3a: extension of gas into perinephric space
Class 3b: extension of gas into pararenal space
Class 4: Bilateral or solitary kidney.
